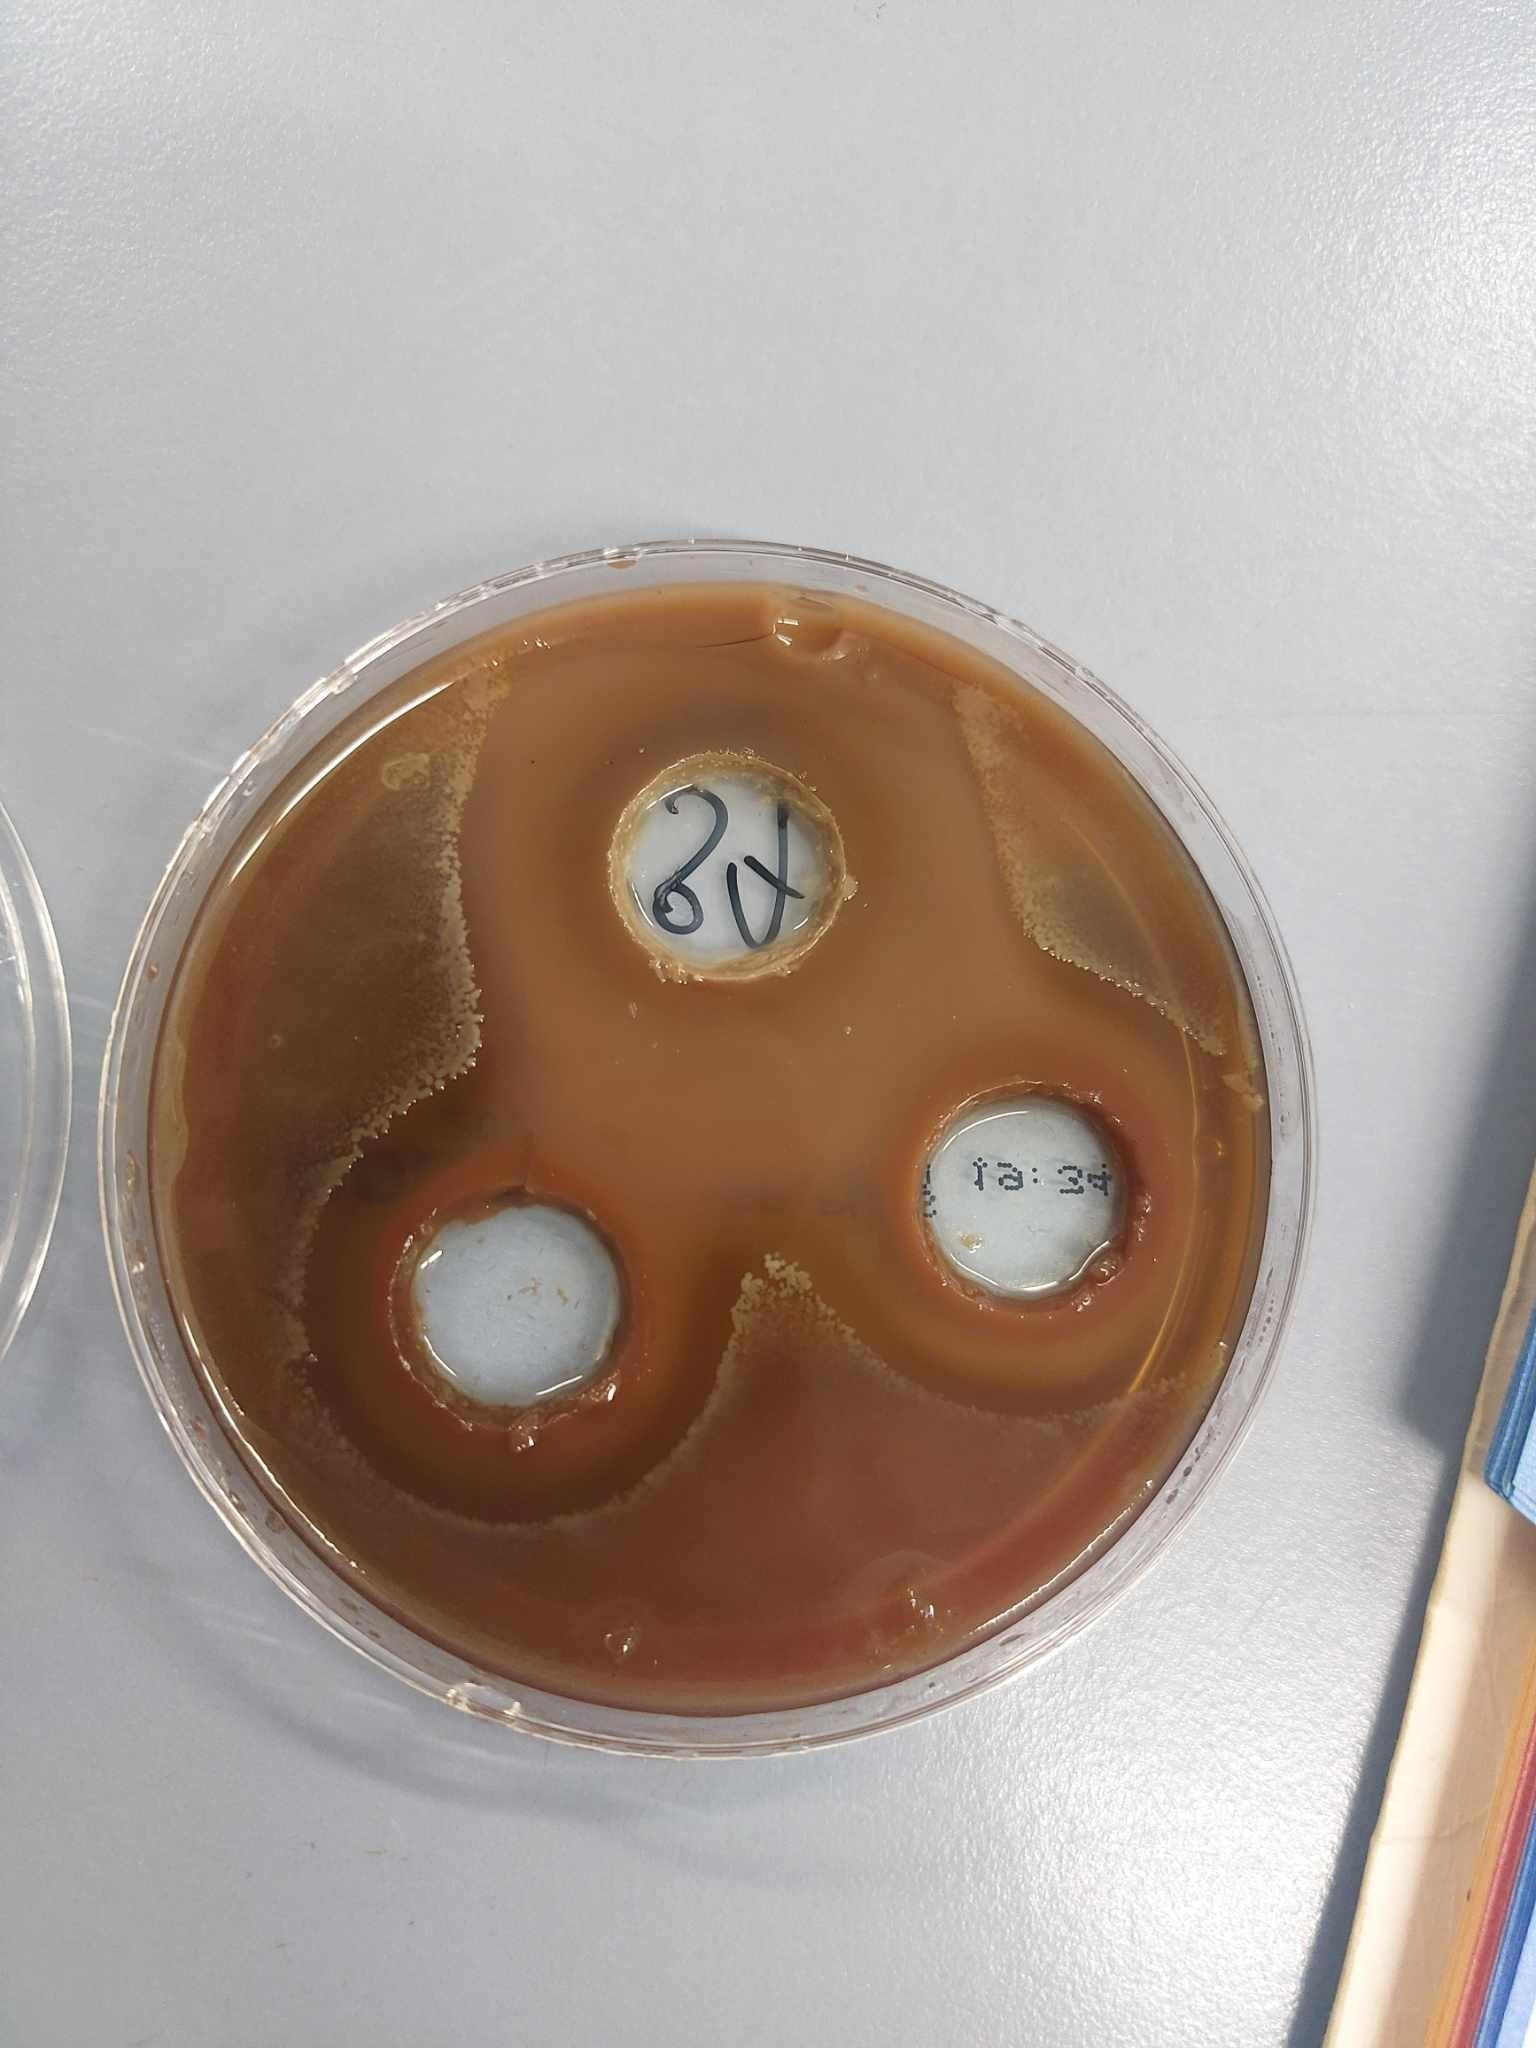

Mariaż biotechnologii i mikrobiologii okazał się sukcesem. Piotr Nowotnik, doktorant IV roku kształcenia w Szkole Doktorskiej UPWr w dyscyplinie weterynaria, z wykształcenia biotechnolog, specjalista w mikrobiologii na polu swoich naukowych badań właśnie odniósł sukces. Od wielu lat zajmowały go badania zjawiska przeciwdrobnoustrojowości i oporności patogenów środowiskowych na różne czynniki przeciwbakteryjne, które rozpoczął jeszcze w Szkole Głównej Gospodarstwa Wiejskiego w Warszawie.
Sukces polskiego naukowca
Naukowiec w ramach doktoratu wdrożeniowego we współpracy z firmą @ProBiotics Polska opracowuje pierwszy w Europie preparat metaboliczny – synbiotyczny o podwyższonym potencjale przeciwdrobnoustrojowym, zmniejszającym presję bakterii Paenibacillus larvae na fizjologiczny mikrobiom larw rodzin pszczelich. Dzięki temu pszczoły nie przekazują dalej choroby i jednocześnie zmniejsza się częstotliwość występowania ognisk zgnilca amerykańskiego w pasiekach. Piotr Nowotnik jako jedyny w Polsce uzyskał zgodę Głównego Lekarza Weterynarii na przeprowadzanie badań terenowych z udziałem zakażonych rodzin pszczelich. – Specjalna, fermentowana formuła preparatu, stosowana w formie prewencyjnej przez pszczelarzy, będzie zawierała killerowe szczepy probiotyczne i komponenty roślinne pochodzące z polskich lasów i łąk – czytamy w materiale prasowym Uniwersytetu Przyrodniczego we Wrocławiu.
Naukowiec za cel postawił sobie:
- wzmocnienie mikrobiomu larw i dorosłych osobników pszczoły miodnej,
- wyeliminowanie rozprzestrzeniania się bakterii P. larvae (przerwanie łańcucha zakażeń),
- opracowanie sposobu, dawkowania i drogi podania preparatu z uwzględnieniem elementów praktyki pszczelarskiej,
- ograniczenie wzrastającej liczby terenów zapowietrzonych i skutecznie zredukowanie rozszerzających się ognisk zakaźnych,
- opracowanie i dostarczenie nowego, kontaktowego synbiotyku o wysokim potencjale przeciwdrobnoustrojowym dla pszczół, zabezpieczającego przed zakażeniem bakterią Paenibacillus larvae wywołującą zgnilec amerykański w rodzinach pszczelich.
Preparat zwalczający zgnilca amerykańskiego
Doktorat ten składał się z 23 zadań obejmujących badania laboratoryjne in-vitro, badania terenowe in vivo oraz prace przedwdrożeniowe. Sprawdzanie skuteczności i bezpieczeństwa preparatu miało miejsce na terenie 64 pasiek podstawowych i 98 pasiek rezerwowych u ponad 400 rodzin pszczelich w Polsce i zagranicą. Po wielu analizach i eksperymentach można stwierdzić, że nowy preparat ogranicza i zapobiega infekcjom w ulach, a do tego jest w pełni bezpieczny, ekologiczny, nie wykazuje toksyczności dla pszczół ani środowiska. Aplikowany będzie w formie dodatku do pokarmu lub poprzez nakraplanie uliczek międzyramkowych obsiadanych przez pszczoły w ulu. Rejestracja została ukierunkowana na mieszankę paszowo-uzupełniającą.
Przeczytaj także: Są pieniądze dla pszczelarzy! Można składać wnioski o dofinansowanie do ARiMR
Doktorat Piotra Nowotnika
Warto wymienić osoby, które wspomagały naukowca:
- opieka promotorska – Pan Profesor Paweł Chorbiński z @Uniwersytetu Przyrodniczego we Wrocławiu,
- praca doktorska oraz realizacja metodologii – wsparcie Pana Profesora Pawła Migdała z @Uniwersytetu Przyrodniczego we Wrocławiu i Pana Doktora Bogusława Górskiego z firmy @ProBiotics Polska,
- kontrola jakości oraz przygotowywanie szczepów bakteryjnych do dalszych analiz – pomoc Zespołu Mikrobiologów z Instytutu Technologii Mikrobiologicznych w Turku na czele z Panem Michałem Świątkiem oraz Dyrektor ITM – Panią Małgorzatą Stefańską-Jońca.
Źródło: materiały prasowe
fot. Piotr Nowotnik, Marek Gacka